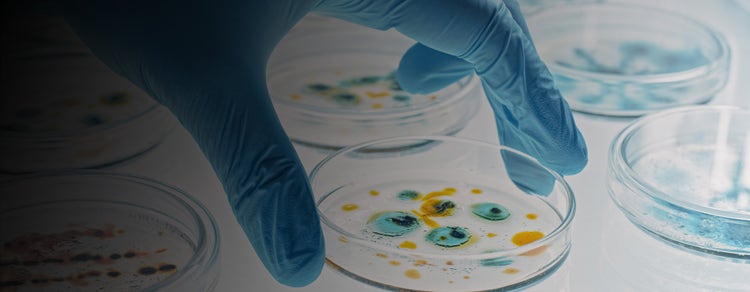

What is Cell Line Development?
Cell line development is the process of generating a genetically stable, single-cell–derived production line that expresses a protein, antibody, or viral vector of interest at consistent levels.
In most programs, this means:
- Introducing target DNA into host cells such as CHO or HEK293
- Isolating and expanding individual cells into monoclonal colonies
- Documenting proof of clonality through imaging and growth tracking
- Screening and ranking high-producing clones
- Scaling those clones for CGMP manufacturing
The resulting stable cell line forms the foundation for biologics, monoclonal antibody (mAb), and gene therapy production pipelines.

Cell line development process:
-
Stable Transfection
Introduce DNA encoding the gene of interest into the host cell (often CHO or HEK293). The goal is to achieve stable cell line generation, where the transgene integrates into the genome and remains stably expressed.
This foundation determines long-term productivity and clone stability. -
Pool Enrichment
Following transfection, not all cells express the transgene effectively. Pool enrichment selects for cells with higher expression or productivity, improving the probability of finding high-producing clones downstream.
Expression-based enrichment and selective pressure ensure the next stage begins with the most promising sub-population. -
Single-Cell Isolation
At this stage, individual cells are isolated from the enriched pool to ensure each clone originates from a single progenitor.
This marks the transition from a mixed population to a traceable lineage — the foundation of monoclonality assurance and proof of clonality required for CGMP-readiness. -
Monoclonality Verification & Growth
Each isolated cell is monitored as it expands into a colony. Sequential imaging confirms that growth originates from one cell, providing the documentation required for monoclonality verification.
This phase ensures the cell line is both clonal and viable, ready for productivity evaluation and regulatory submission. -
Titer & Critical Quality Attribute (CQA) Screening
Monoclonal colonies are evaluated for productivity and critical quality attributes (CQAs) — such as titer, purity, and post-translational modifications.
This is where clone productivity screening identifies high-producing, stable clones that advance into scale-up and manufacturing.